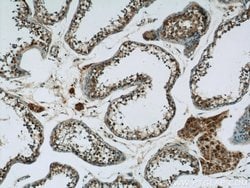
CDC45L Rabbit anti-Human, Mouse, Rat, Polyclonal, Proteintech 150 &mu;L;

missing translation for 'onlineSavingsMsg'
Learn More
Learn More
CDC45L Rabbit anti-Human, Mouse, Rat, Polyclonal, Proteintech
Rabbit Polyclonal Antibody
Brand: Proteintech 15678-1-AP-150UL
This item is not returnable.
View return policy
Description
This is a rabbit polyclonal antibody raised against part of C-terminus of human CDC45L.
The protein encoded by this gene was identified by its strong similarity with Saccharomyces cerevisiae Cdc45, an essential protein required to the initiation of DNA replication. Cdc45 is a member of the highly conserved multiprotein complex including Cdc6/Cdc18, the minichromosome maintece proteins (MCMs) and DNA polymerase, which is important for early steps of DNA replication in eukaryotes. This protein has been shown to interact with MCM7 and DNA polymerase alpha. Studies of the similar gene in Xenopus suggested that this protein play a pivotal role in the loading of DNA polymerase alpha onto chromatin. Multiple polyadenlyation sites of this gene are reported.Specifications
| CDC45L | |
| Polyclonal | |
| Unconjugated | |
| CDC45 | |
| CDC45, CDC45L, CDC45L2, PORC PI 1 | |
| Rabbit | |
| Antigen Affinity Chromatography | |
| RUO | |
| 12544, 287961, 8318 | |
| -20°C | |
| Liquid |
| Flow Cytometry, Immunocytochemistry, Immunofluorescence, Immunohistochemistry (Paraffin), Immunoprecipitation | |
| 0.31 mg/mL | |
| PBS with 50% glycerol and 0.02% sodium azide; pH 7.3 | |
| O75419, Q9Z1X9 | |
| Cdc45 | |
| CDC45L Fusion Protein Ag8150 | |
| 150 μL | |
| Primary | |
| Human, Mouse, Rat | |
| Antibody | |
| IgG |
Product Content Correction
Your input is important to us. Please complete this form to provide feedback related to the content on this product.
Product Title
Spot an opportunity for improvement?Share a Content Correction